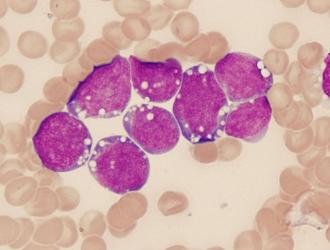

L’Azienda Ospedali Riuniti Villa Sofia è stata accreditata come centro prescrittore della nuova terapia CAR-T per contrastare le leucemie e i linfomi. Sarà l’Unità Operativa Complessa di Ematologia, diretta da Francesco Fabbiano, ad applicare questa rivoluzionaria terapia cellulare per le neoplasie...
CAR-T
L’Agenzia Italiana del Farmaco (AIFA) ha dato il via libera alla rimborsabilità della prima terapia a base di cellule CAR-T (Chimeric Antigen Receptor T-cell) disponibile in Italia.
La nuova terapia, denominata Kymriah (tisagenlecleucel), potrà essere prescritta secondo...
Manipolare geneticamente le cellule del sistema immunitario per renderle capaci di riconoscere e attaccare il tumore. È quello che hanno fatto i medici e i ricercatori dell’Ospedale Pediatrico Bambino Gesù di Roma con un bambino di quattro anni, affetto da leucemia linfoblastica acuta...
Le difese dell'organismo nascondono il segreto di un modo nuovo di combattere i tumori: basta rieducarle con la terapia genica per dotarle di una corazza anticancro. È la nuova frontiera dell'immunoterapia basata su cellule immunitarie modificate chiamate CAR-T...
Via libera negli USA ad una terapia genica che potrebbe rivoluzionare la cura di molti tumori. Infatti, l'FDA (Food and Drug Administration) ha approvato il trattamento chiamato CAR-T, che consiste nell'utilizzare le cellule del sistema immunitario del paziente ingegnerizzate, per ora contro la leucemia...